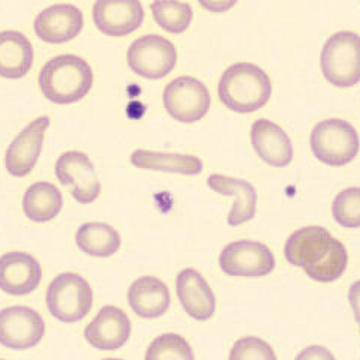
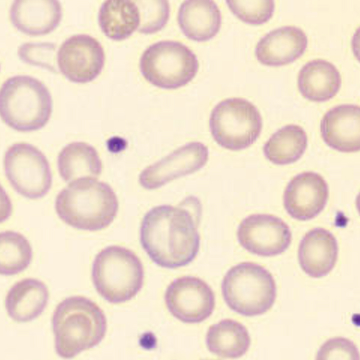
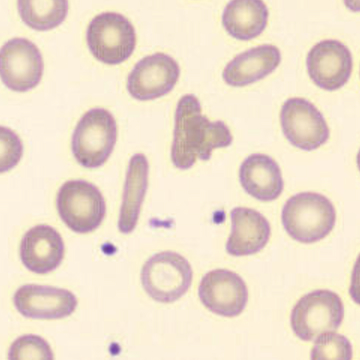
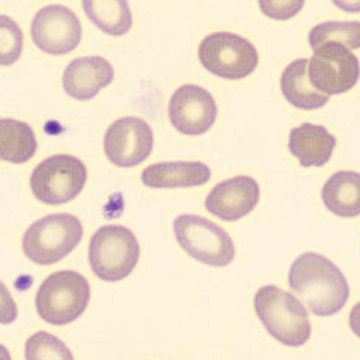

Elliptocytes
Synonyms: Ovalocytes
Elliptocytes (also ovalocytes) are erythrocytes with an elongated, oval to cigar-shaped morphology. They arise from structural defects in the erythrocyte cytoskeleton, particularly in spectrin, ankyrin and band 4.1.
They are seen in hereditary elliptocytosis, iron deficiency anemia, megaloblastic anemia, myelodysplastic syndrome and thalassemias, among others. An increased proportion of elliptocytes in peripheral blood (>10-15%) is suggestive of a membrane abnormality or disturbed erythropoiesis, but is not diagnostic by itself.